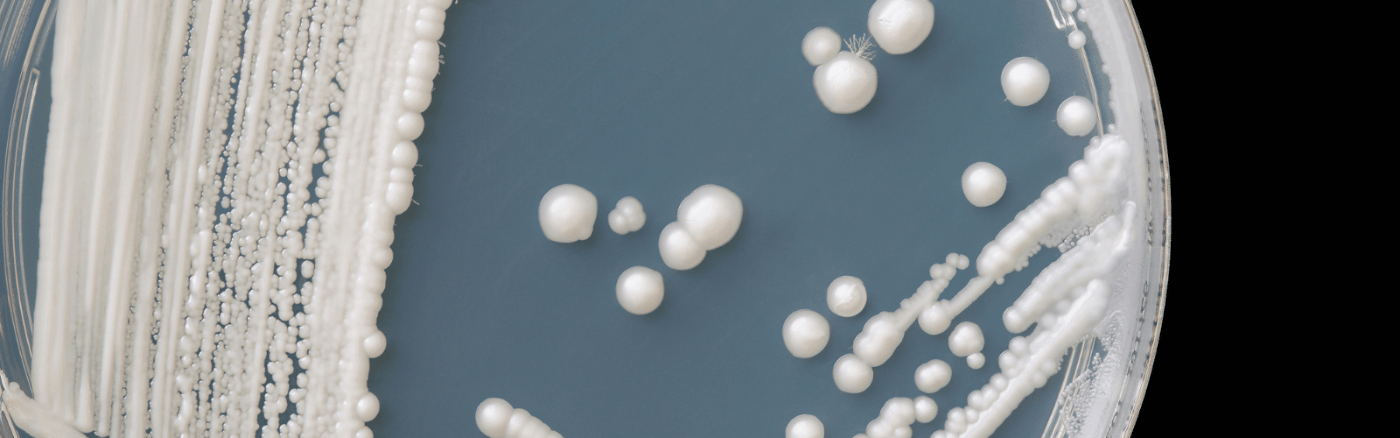
medicijnen schimmelinfectie
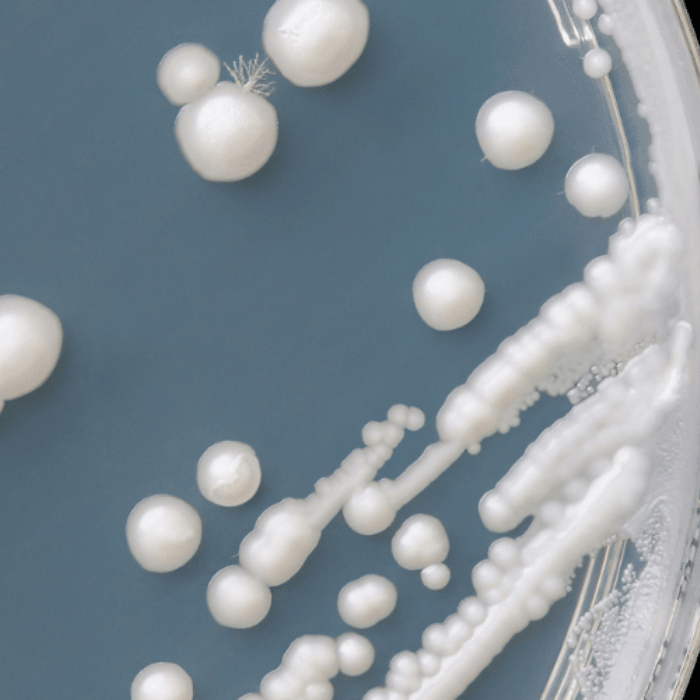
medicijnen schimmelinfectie

Wat is een schimmelinfectie?
Een schimmelinfectie wordt ook wel mycose genoemd. Het is een bepaalde aandoening dat wordt veroorzaakt door een overgroei aan schimmels. Schimmels zijn microscopische organismen die van nature ook op ons lichaam voorkomen. Hier merk je niets van.
Tenzij het evenwicht van schimmels uit balans raakt. De balans tussen bacteriën en schimmel verandert, waardoor er een infectie ontstaat. Deze schimmelinfectie kan op verschillende plekken van het lichaam voorkomen. En zowel op de huid, nagels en slijmvliezen. De infectie is meestal niets om je zorgen over te maken, maar kan wel erg vervelend zijn. Gelukkig is de infectie vaak goed te behandelen.

Verschillende soorten schimmelinfectie
De symptomen en de ernst van een schimmelinfectie varieert per type infectie en per getroffen gebied. Hier zijn enkele veelvoorkomende voorbeelden van schimmelinfecties bij mensen:
Vaginale schimmelinfecties
Een veelvoorkomende infectie bij vrouwen is een infectie aan de vagina. Het wordt meestal veroorzaakt door de schimmel Candida albicans. Klachten treden op aan zowel de binnenkant van de vagina als aan de schaamlippen. De schaamlippen worden roder, kunnen zwellen en doen soms zeer. Ook treedt er overgevoeligheid op tijdens het vrijen en plassen.
Huidschimmel
Ook huidschimmel komt regelmatig voor. Schimmelinfecties aan de huid geven vaak typerende klachten, als: roodheid, jeuk, huiduitslag en schilfers. Deze schimmelinfecties aan de huid kunnen over het hele lichaam ontstaan. Wel zie je ze sneller aan de voeten optreden, omdat dit een prettige leefomgeving is voor schimmels.
Schimmelnagelinfectie
Naast schimmelinfectie aan de vagina en huid, kan de schimmel ook toenemen op de nagels. Ze veroorzaken verdikking, pijn, verkleuring en broosheid van de nagels. Meestal gaat het hierbij om de teennagels, maar ook de vingernagels kunnen aangedaan zijn.


Wat is een schimmelinfectie van de vagina?
Een bekend en vooral veelvoorkomende schimmelinfectie is de vaginale schimmel. Een vaginale schimmel, ook wel candidiasis genoemd, is een infectie dat wordt veroorzaakt door de overgroei van de schimmel Candida. Meestal gaat het om de Candida Albicans.
De schimmel is van nature aanwezig in de vagina. Hier merk je verder niets van. Maar bij bepaalde omstandigheden kan de schimmel zich vermenigvuldigen en zo klachten veroorzaken, als: jeuk, roodheid. Er zijn verschillende factoren die het ontstaan van schimmelinfecties aan de vagina kunnen veroorzaken, waaronder:
Antibioticagebruik
Het nemen van antibiotica kan een oorzaak van de schimmelinfectie zijn. Antibiotica remt namelijk bepaalde bacteriën. Hierdoor kunnen schimmels de overhand krijgen. En als er meer schimmels dan bacteriën aanwezig zijn, kan dit voor een schimmelinfectie zorgen. Dit gebeurt vooral bij langdurig antibiotica gebruik.
Hormonale schommelingen
Ook schommelingen in hormoonniveaus kunnen de kans op een schimmelinfectie vergroten, omdat een verandering in hormonen automatisch ook effect heeft op de vrouwelijke flora. Hierdoor ontstaat er bijvoorbeeld een vergroot risico op een schimmelinfectie tijdens de zwangerschap, na je menstruatie of bij gebruik van bepaalde anticonceptie.
Verzwakt afweersysteem
Een verzwakt immuunsysteem vergroot ook het risico op een schimmelinfectie. Je lichaam is dan namelijk minder goed in staat om zich tegen de schimmel te verdedigen. Hierdoor ontstaat er gemakkelijker een infectie.


Symptomen van een vaginale schimmel
De symptomen van vaginale schimmelinfecties kunnen variëren. Maar de meest voorkomende zijn: jeuk en roodheid, een branderig gevoel in de vagina en vulva (buitenste genitale gebied), witte brokkelige afscheiding en zwelling van het slijmvlies van de vagina. Ook zijn de schaamlippen vaak gevoeliger en gezwollen. Daarnaast doet de vagina bij veel vrouwen pijn tijdens het vrijen.
Als je twijfelt over je klachten kan het wel verstandig zijn om een huisarts te bezoeken. Soms kunnen de symptomen namelijk ook een beetje lijken op een bacteriële vaginose (overgroei bacteriën) of seksueel overdraagbare infecties. Een huisarts kan een juiste diagnose stellen en de juiste behandeling aanbevelen.
Vaginale schimmelinfectie behandelen (medicijnen schimmelinfectie)
Als je denkt dat je een vaginale schimmel hebt, is het niet altijd noodzakelijk om hier iets tegen de doen. In de meeste gevallen gaat een schimmelinfectie namelijk vanzelf weer weg. Blijven de klachten aanhouden? Of zijn ze gewoonweg erg vervelend? Dan kan er wel voor gekozen worden om de infectie te behandelen. Meestal gebeurt dit met de schimmeldodende middelen: miconazol of clotrimazol. Die in de vorm van crèmes, zetpillen of tabletten verkrijgbaar zijn.
Deze geneesmiddelen kunnen rechtstreeks in de vagina worden ingebracht en/of gesmeerd worden op de schaamlippen. Afhankelijk van het type middel. Ze werken lokaal om de schimmelinfectie te behandelen. Het is belangrijk om de instructies van de bijsluiter goed te volgen. Als de symptomen blijven aanhouden of de schimmelinfectie regelmatig terugkeert kan een huisarts sterkere medicijnen voorschrijven.


Voetschimmel
Naast een vaginale schimmelinfectie, komt ook voetschimmel veel voor. Deze schimmelinfectie wordt ook wel Tinea pedis genoemd en tast de huid van de voeten aan. Het wordt veroorzaakt door schimmels die graag leven in warme, vochtige omgevingen. Zoals in je schoenen en sokken.
In sommige gevallen kan voetschimmel zich ook verspreiden naar andere delen van de voet. Zoals de voetzolen en de nagels. Een schimmelinfectie aan de voeten varieert in ernst en symptomen. Wel zijn er een aantal typische klachten:
- Jeukende huid, meestal tussen de tenen
- Schilferende huid
- Roodheid en geïrriteerde huid
- Soms kleine blaasjes of kloven
- Branderig gevoel of pijn


Oorzaak voetschimmel
Schimmels zijn micro-organismen die zich voeden met keratine. Dit is een eiwit dat in de huid, nagels en haren zit. Wanneer schimmels zich vermenigvuldigen en groeien op de huid van de voeten, kan dit een schimmelinfectie aan de huid veroorzaken. De warme, vochtige omgeving van de voeten, vooral in gesloten schoenen, creëert de ideale omstandigheden voor schimmels om zich te ontwikkelen.
Behandeling van voetschimmel (medicijnen schimmelinfectie)
Voetschimmel is doorgaans goed te behandelen met geneesmiddelen die een schimmel dodende werking hebben. Er zijn zowel vrij verkrijgbare crèmes en sprays als voorgeschreven geneesmiddelen beschikbaar. Veel voorkomende werkzame bestanddelen in deze medicijnen zijn miconazol of clotrimazol. Die de schimmelgroei remmen.
Naast geneesmiddelen zijn er ook nog enkele preventieve maatregelen die je kunt nemen om de kans op voetschimmel of het risico op een terugkerende infectie te verkleinen: houd je voeten goed schoon en droog, draag ademende schoenen en vocht absorberende sokken, vermijd het delen van schoenen met anderen, sokken en handdoeken en laat schoenen goed luchten en drogen na gebruik.
In gevallen waarin de voetschimmel ernstig is of zich heeft verspreid, is het raadzaam om een arts te raadplegen voor een juiste diagnose en behandelingsopties. Onbehandelde voetschimmel kan leiden tot pijnlijke complicaties en verdere verspreiding van de infectie.


Zelf schimmelinfectie behandelen
Twee bekende voorbeelden van middelen tegen een schimmelinfectie zijn: anti schimmel creme en anti schimmel pillen. Schimmelinfectiepillen worden ook wel orale antischimmelmedicijnen genoemd. Deze zijn op recept verkrijgbaar en neem je via de mond in.
Schimmelinfectie pillen (medicijnen schimmelinfectie)
Anti schimmelinfectie pillen worden in je bloedbaan opgenomen en bestrijden de schimmel op die manier van binnenuit. Ze worden vaak voorgeschreven bij ernstige of terugkerende schimmelinfecties, zoals vaginale schimmelinfecties, schimmelnagelinfecties of bepaalde systemische schimmelinfecties in het lichaam.
Anti schimmel creme
Antischimmelcrème, ook wel topische antischimmelmedicatie genoemd, is een vorm van medicatie dat rechtstreeks op de huid wordt aangebracht. Het wordt gebruikt om oppervlakkige schimmelinfecties te behandelen, zoals voetschimmel, ringworm, candidiasis op de huid of schimmelinfecties in huidplooien. Deze crèmes bevatten actieve ingrediënten, als clotrimazol of miconazol. Die lokaal op de huid werken om de schimmelgroei te remmen en de infectie te behandelen.
Middelen schimmelinfectie apotheek kopen
Als je last hebt van een schimmelinfectie is het meestal niet nodig om een huisarts te bezoeken voor een recept. De meest geneesmiddelen tegen een schimmelinfectie zijn namelijk zonder recept verkrijgbaar. Ook bij Boots apotheek kun je terecht voor mediceen anti schimmel creme. Bekijk hierboven ons complete assortiment!



















